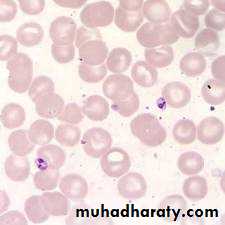

Lishmaniasis
Life cycleL. Donovane.
L. Tropica.L. barazerliensis .
L . Mexicana.
Immunity
Cellular reaction.Delayed hypersensitivity.
In visceral lishmaniasis:increase in Immunoglobulin G
Lishmania donovani(kala azar, Visceral leishmaniasis)
Epidemiology
Indian.Mediterranean.
Sudanese.
Vector :
Sand fly(Phlebotomus).Source of infection :
Humans & dogs.Transmission:
Bite of sand fly.Blood transfusion.
Congenital ( rare).
Pathology
Symptoms & signs.Diagnosis.
Clinical picture.
blood or tissue parasite.
Serology.
Culture: NNN media, animal inoculation.
Treatment
General :Pentavalent Antimony drugs.
Prevention.
Post Kala azar dermal leishmaniasisCause:
Immune reaction due to incomplete treatmentLishmania tropica( Oriental sore, Baghdad boil, cutanous leishmaniasis)
Dry ( urban).Moist ( rural ).
Epidemiology
Transmission: Sand fly ( phlebotomus after cyclic development).Contact infection.
Autoinoculation ( scratching).Pathology
Limited to the skin on exposed sites.
Amastigotes : ( intracellular in macrophages & histiocytes).
Papule , dry white scales , moist brown scales, crust covering an ulcer, surrounded induration, Healing by scar.
Diagnosis
Clinical pictureSmear : scraping the edge of the lesion.
Serum from the indurated edge .
Culture
Treatment
Pentavalant antimony comp.Local :